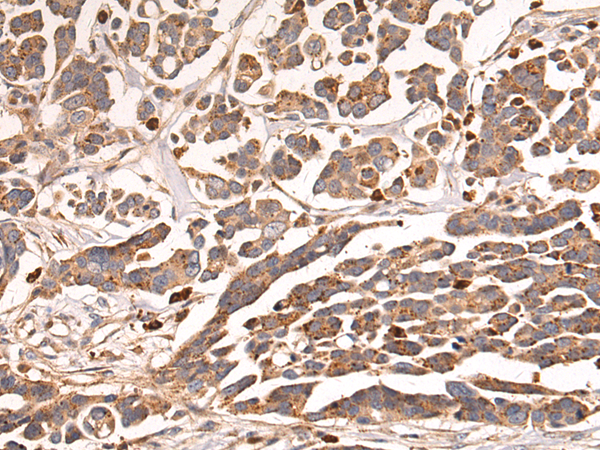
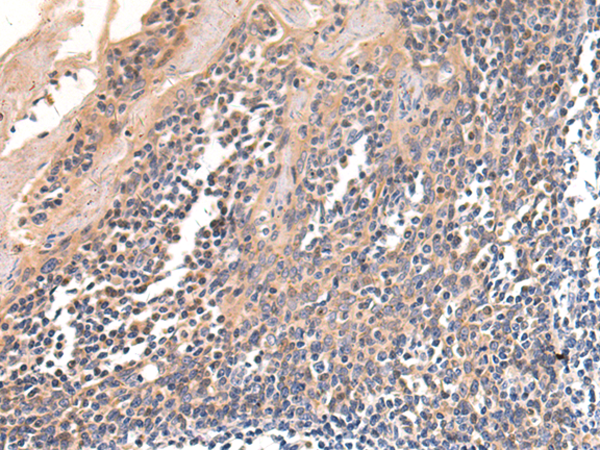

-
分类: 科研抗体货号: P10960别名: TP2; TRT; CMM9; EST2; TCS1; hTRT; DKCA2; DKCB4; hEST2; PFBMFT1应用: WB,IHC反应种属: Human
-
分类: 科研抗体货号: P10937别名:应用: WB,IHC反应种属: Human, Mouse, Rat
-
分类: 科研抗体货号: P10959别名: DE; SPD; BDSD; HOX4I应用: WB反应种属: Human, Mouse
-
分类: 科研抗体货号: P10935别名: BIP; GRP78; HEL-S-89n应用: WB,IHC反应种属: Human, Mouse, Rat
-
分类: 科研抗体货号: P10958别名: HOX1, HOX1D应用: IHC反应种属: Human
-
分类: 科研抗体货号: P10934别名: BARK1; ADRBK1; BETA-ARK1应用: IHC反应种属: Human, Mouse, Rat
-
分类: 科研抗体货号: P10957别名: HOX1, HOX1I应用: WB反应种属: Human, Mouse
-
分类: 科研抗体货号: P10933别名: RK, RHOK, GPRK1应用: IHC反应种属: Human, Mouse, Rat
-
分类: 科研抗体货号: P10954别名: HMG4, HMG-4, HMG2A, HMG-2a应用: WB,IHC反应种属: Human, Mouse
-
分类: 科研抗体货号: P10932别名: HH7; GRHR; LRHR; LHRHR; GNRHR1应用: WB,IHC反应种属: Human, Mouse

鄂公网安备42018502007531号
鄂公网安备42018502007531号

